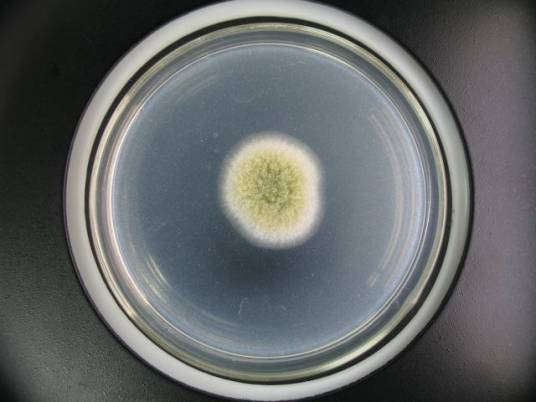

-
米曲霉 编辑
米曲霉(Aspergillus oryzae)属于黄曲霉群,是曲霉属中的一个常见种。分生孢子头放射状,一直径150-300μm,也有少数为疏松柱状。分生孢子梗2mm左右。分生孢子梗长约2mm,近顶囊处直径达12-25μm,壁较薄,粗糙。顶囊近球形或烧瓶形,通常40-50μm。小梗一般为单层,12-15μm,偶尔有双层,也有单、双层小梗同时存在于一个顶囊上。分生孢子幼时洋梨形或卵圆形,老后大多变为球形或近球形,一般4.5μm,粗糙或近于光滑。米曲霉菌落生长快,10d直径达5-6cm,质地疏松。初呈白色、黄色,后转黄褐色至淡绿褐色,背面无色,分布甚广,主要在粮食、发酵食品、腐败有机物和土壤等处。是我国传统酿造食品酱和酱油的生产菌种。也可生产淀粉酶、蛋白酶、果胶酶。
米曲霉培养皿
米曲霉孢子只要吸收到水分和养料,有空气和适宜的温度、湿度,就立刻开始发芽,生出管子一样的白色菌丝,菌丝会伸展很长,中间有横隔膜分开形成多细胞,每个细胞内又有几个细胞核,所以米曲霉的细胞是一种多核的细胞。
环境条件越好越有利于菌丝生长发育。当菌丝生长到一定阶段时,部分细胞壁变厚形成足细胞,由此向上长出2mm左右长的分生孢子梗(通常称直立菌丝),很整齐,形似一层白绒。
分生孢子梗上再生长出膨大的顶囊,近球形,其直径为40-50μm。
顶囊上会再生出小梗,小梗绝大多数是单层,其大小为(12-15)μmx(3-5)μm,在小梗上再生长出茂密的孢子(分生孢子),在显微镜下观看形似一朵盛开了的菊花,非常美丽。米曲霉从孢子发芽,生长菌丝,荐由菌丝长出分生孢子梗,在分生孢子梗上生长出顶囊,顶囊上再长出小梗,最后在小梗上长m孢子至老熟,就是一代。一般培养24个小时左右就能生长出孢子,初为嫩黄色,经过2-3天时间逐渐变成黄绿色,衰老时孢子变为褐色。
米曲霉在察氏培养基上菌落形成较快,培养10天后菌落直径可达5-6cm,质地疏松,初期为嫩黄色,后变为黄绿色直至褐色,反面无色。在黄豆汁培养基上菌落形成更快,培养24个小时左右就能生出孢子,初为嫩黄色,继而逐渐变成黄绿色,到孢子衰老也只需培养2-3天时间。最后衰老时,孢子变为褐色。
由此可见米曲霉的形态特征是:米曲霉的基本组成是菌丝(包括气生菌丝和营养菌丝)和孢子,菌丝中有横隔膜,每一段就是一个细胞,整个菌丝体由多细胞、多核细胞构造成,曲霉菌丝宽大,一般宽度为3-10μm。
营养物质
米曲霉生长所需的营养物质,主要包括碳素化合物(通常简称为碳源)、氮素化合物(通常简称为氮源)、无机盐类、水和生长因素。
碳源:凡可以构成微生物细胞和代谢产物中碳架的营养物质称为碳源。总的来说,大多数微生物以有机含碳化合物作为碳源和能源,如糖类(主要有单糖、双糖、多糖)、醇类、有机酸、脂肪、烃类等含碳的有机物。其中糖类是最好的碳源,特别是葡萄糖、蔗糖,通常作为培养微生物的主要碳素原料。
碳源的主要作用是构成细胞物质和供给米曲霉生长发育所需要的能量。从微生物细胞化学成分的分析中已知细胞中的碳素含量相当高,占干物质的50%左右,也就是说,在微生物的营养需要中,对碳的需要量最大。
氮源:凡是构成微生物细胞物质或代谢产物中氮素来源的营养物质称为氮源。氮源分为无机氮和有机氮,有机氮主要有蛋白质、氨基酸、尿素、胺等;无机氮主要有氨盐、硝酸盐等。氮源对微生物的生长发育有重要作用,主要是提供合成原生质和细胞其他结构的原料,一般不提供能量。
在米曲霉的生命活动中,氮源是不可缺少的营养物质,是构成米曲霉细胞蛋白质、核酸和酶的主要元素。
微量元素:除了上述各种元素外,微生物维持正常的生长发育常常需要一些微量的钼、锌、锰、钴、镍、铜、碘、溴、钒等。它们极微量的存在往往非常强烈地刺激微生物的生命活动。这是由于许多微量元素参加组成酶蛋白,或者很多酶受它们的活化。由于这些微量元素常混在其他营养物质和水中,所以培养基中一般不另行添加。
无机盐类:无机盐类也是米曲霉生命活动中不可缺少的物质。它的主要功能是构成细胞的组成成分;作为酶的组成成分;维持酶的作用;调节细胞渗透压、氢离子浓度、氧化还原电位等。如磷和硫还是构成蛋白质和核酸的主要成分,磷酸盐还具有维持酶活性和调节pH的作用。
一般微生物需要的无机盐类包括硫酸盐、磷酸盐、氯化物,以及含钠、钾、镁、铁、钙等的化合物。
水:水是微生物肌体的重要组成成分。水在微生物代谢过程中也占极重要的地位,除了直接参加一些代谢反应外,还是进行代谢反应的内部介质。物质必须先溶于水,才能参加代谢反应。此外,微生物没有特殊的摄食及排泄器官,它的营养物、代谢产物必须溶解于水,才能通过细胞表面。
水的比热高,能够有效地吸收微生物代谢过程中所放出的热量,使细胞内温度不致骤然上升;同时,由于水又是热的良导体,有利于散热,因此可以调节微生物细胞的温度。微生物离开水便不能进行生命活动。
生长因素:有些微生物在具有合适的水分、碳源、氮源、无机盐的条件下,仍不能生长或生长不好。如果加入少量的某些微生物所必需的有机物质,如维生素、氨基酸,则会生长良好。这些有机物是微生物维持正常生命活动所不可缺少而需要量又不大的特殊营养物质,一般称之为生长因素或生长因子。
繁殖方式
米曲霉是利用孢子繁殖的。孢子先吸水膨胀,在适宜的环境条件下孢子发芽,即在孢子表面长m一个或多个芽管,逐渐伸长,并不断长出分枝,结成网状的菌丝体,再由菌丝长出分生孢子梗,在分生孢子梗顶囊上再生出小梗,小梗上着生孢子直至老熟,就是一代。
生长条件控制
米曲霉孢子粉
水分:生长水分为34%-45%,相对湿度为95%左右;
温度:孢子发芽温度为28℃-32℃,生长温度为32℃-35℃,产酶最适宜温度为28℃-30℃;
pH:适宜pH范围为4.5-7.5,适宜生长的pH范围为6.5-6.8。
产毒最适温度为24-30℃,最适相对湿度为85%-90%。
1、本站所有文本、信息、视频文件等,仅代表本站观点或作者本人观点,请网友谨慎参考使用。
2、本站信息均为作者提供和网友推荐收集整理而来,仅供学习和研究使用。
3、对任何由于使用本站内容而引起的诉讼、纠纷,本站不承担任何责任。
4、如有侵犯你版权的,请来信(邮箱:baike52199@gmail.com)指出,核实后,本站将立即删除。